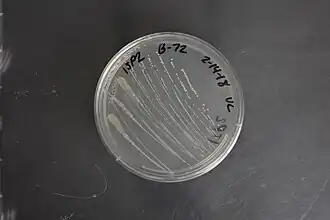

Gluconobacter is een van de vijf geslachten van azijnzuurbacteriën. Genetisch onderzoek plaatst deze bacteriën bij de Proteobacteria en zij behoren tot de orde van de Rhodospirillales.
Soorten
- Gluconobacter albidus
- Gluconobacter asaii
- Gluconobacter cerevisiae (geïsoleerd uit lambiekbier en in 2014 voorgesteld als een nieuwe soort)[1]
- Gluconobacter cerinus
- Gluconobacter frateurii
- Gluconobacter japonicus
- Gluconobacter kanchanaburiensis
- Gluconobacter kondonii
- Gluconobacter nephelii
- Gluconobacter oxydans (waarschijnlijk de bekendste wegens zijn toepassingen in de biotechnologie)[2]
- Gluconobacter roseus
- Gluconobacter sphaericus
- Gluconobacter thailandicus
- Gluconobacter uchimurae
- Gluconobacter wancherniae
Externe link
Bronnen, noten en/of referenties
- ↑ Gluconobacter cerevisiae sp. nov., isolated from the brewery environment, Spitaels F, Wieme A, Balzarini T, Cleenwerck I, Van Landschoot A, De Vuyst L, Vandamme P., Laboratory of Microbiology, Faculty of Sciences, Universiteit Gent, april 2014, NCBI
- ↑ Gluconobacter oxydans. Gearchiveerd op 4 oktober 2022.